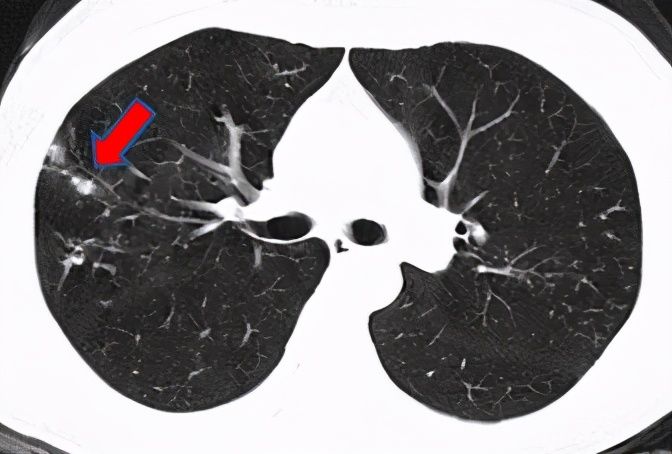
结节|刀下“留肺”!容易误认为癌性“肺结节”的8种感染

文章插图
对于这个诊断,林先生是抗拒的:肺结核岂不就是肺痨?不是早就被消灭了吗?难道我穿越到鲁迅小说里的民国时代了吗?我家里人和同事们这下可遭殃了!医生安慰他说,结核病千百年阴魂不散,即使在现代文明中也还远远没到消灭的程度,而肺结核正是结核病的最常见发病形式。有的病人有咳嗽咳痰甚至咯血症状,痰里有结核菌,这种肺结核有传染性(也就是开放性肺结核),必须到结核病定点医院诊治;而林先生这种肺结核基本没有传染性,早期发现、及时治疗,一起生活工作的家人和同事也无需担心。
抗结核治疗持续了半年多,吃药复查虽然麻烦,但是眼看着肺结节慢慢变小,林先生也收获了打怪升级的快乐,成功停药。1年后,林先生的肺结节终于全部吸收,打怪结束,喜大普奔!
非结核分枝杆菌赵阿姨是一名普通的家庭妇女,年过半百,只求身体健康,能帮儿女带带孙辈。可是今年她莫名其妙开始咳嗽咳痰,一直不好,最近3个月还时不时发低烧。赵阿姨郁郁寡欢,儿女们急在心里,赶紧预约了医生。胸部CT吓人一跳:两肺有多发结节,赵阿姨乖乖吃了半个月的左氧氟沙星之后复查,没想到结节不仅没消失,反而逐渐增多了,一家人的心都悬了起来。
文章插图
医生安排赵阿姨做支气管镜检查,病理初步排除了肿瘤的可能;又进一步做了国际上最先进的“微生物基因检测”(NGS),确诊赵阿姨为胞内分枝杆菌感染。医生说,这个菌是结核菌的兄弟、是“非结核分枝杆菌”大家族中的一员,没有传染性;治疗时间虽然比较长,但是可以防止肺功能变差,减少对寿命的影响。这下结节病因明确了,赵阿姨心中一块石头落了地。经过细致的治疗,赵阿姨现症状明显好转,重新投入到了带孙辈的“甜蜜的负担”之中。
文章插图
肺吸虫家住江苏的王小姐是个上班族,但平淡的生活却被一阵阵剧烈的咳嗽打断了。干咳到胸痛的王小姐感觉一分钟也忍不了了,半夜去急诊拍了胸部CT,医生看到双肺多发结节影,说不能除外肺癌。王小姐吓得心都提到了嗓子眼,赶紧到感染病科门诊看病。
文章插图
医生看了王小姐病史,发现除了肺结节之外,她的血常规嗜酸性粒细胞更是高到飞起,详细一问,原来王小姐一直喜欢吃醉蟹,鲜嫩的口感让她欲罢不能。医生说,没有煮熟的蟹里很可能有寄生虫,换句话说,你在吃生螃蟹的时候,蟹里的虫也会吃你。
文章插图
在医生建议下,王小姐抽血检查了寄生虫抗体,发现肺吸虫抗体阳性,于是明确诊断:肺吸虫感染。口服药驱虫治疗后,王小姐血常规逐渐恢复正常,胸部CT的结节也吸收了。至此,王小姐长吁一口气,马上在家族群里@所有人:以后都别吃这种没烧熟的东西了。
粗球孢子菌杨阿姨对健康非常重视,每年都体检。但今年的体检有点不妙:胸部CT发现左上肺有一个结节,而且经过随访还有增大的趋势。杨阿姨寝食难安,干脆一步到位去做了PET/CT,看到报告上说的“左肺上叶恶性肿瘤伴xxxx淋巴结转移和xxxx骨转移可能”,她五雷轰顶。但是感染病科医生说,没有病理确诊,还不能说一定是肿瘤,看片子还有良性疾病的可能。杨阿姨仿佛抓住了救命稻草,赶紧住院检查。
文章插图
杨阿姨做了肺穿刺活检,谢天谢地病理报告上说考虑炎症,而微生物基因检测竟检出了她听也没听说过的“粗球孢子菌”。
- 健康|女子意外确诊甲状腺结节,是“生姜”惹的祸?医生辟谣,说出实情
- 1.2厘米的大磨玻璃结节未必是肺癌,反而小结节是原位癌,需警惕
- 63岁大爷患甲状腺结节,通过吃“黄瓜”散结,结果如何?不妨了解
- 肺结节科普系列|肺结节患者,到底该怎么随访?
- 饮食养生|发现胸部有结节?可多吃“二物”,助疏通肿块,为女人的健康护航
- 肺结节|查出肺结节,一定要进行随访吗?肺结节患者,日常如何调养?
- 肺结节的随访时间到底要多久?
- 体检|体检查出甲状腺结节,还能吃海鲜吗?什么食物需要忌口?
- 甲状腺结节患者,多走路有助结节消散?提醒:做好两件事或许更好
- 肺实性结节6mm,经中药治疗10月后,完全消失
